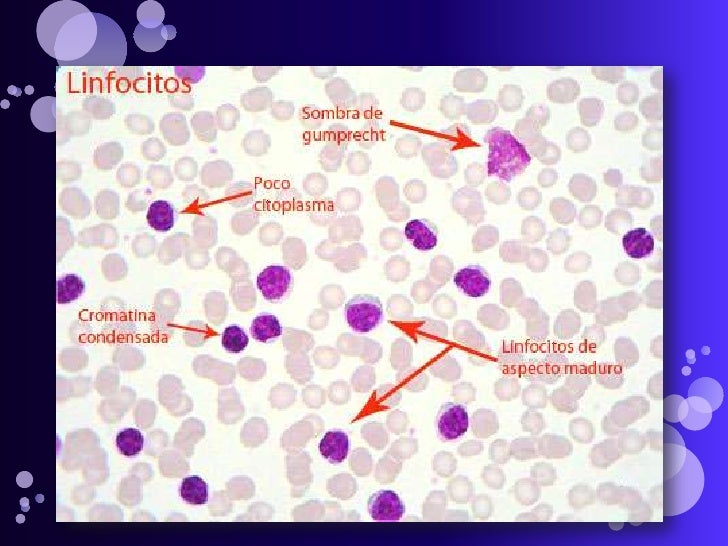
Leucemia linfatica cronica

La leucemia linfocítica crónica, leucemia linfoide crónica, leucemia linfática crónica de células B, también conocida por las siglas LLC (CLL en inglés) es una enfermedad, un tipo de leucemia o cáncer de la sangre que afecta a los glóbulos blancos o leucocitos.[1] En este cáncer los linfocitos maduros son incapaces de cumplir su función inmunitaria,[2] y prolongan su vida anormalmente al disminuir su muerte programada (apoptosis) por lo que aumenta lentamente su número observándose una proliferación en los recuentos sanguíneos y en la médula ósea. En el estado avanzado de la enfermedad el sistema inmunitario, en el que los linfocitos cumplen una importante función, queda debilitado.[3]
En sus primeras fases su curso clínico es indolente (sin síntomas). Admite una gran variabilidad en su pronóstico dependiendo de las variaciones citogenéticas, del inmunofenotipo y de su evolución. Estudios clínicos han mostrado que en las variaciones citogenéticas favorables, la fase indolente de una gran parte de los casos dura más de dos décadas desde su estado inicial hasta necesitar tratamiento.[4] En este grupo la LLC progresa muy lentamente, las personas viven una vida normal y algunos no llegan a necesitar nunca tratamiento.[5] Además, este grupo con pronóstico favorable muestra remisiones duraderas una vez que se aplica un tratamiento.[6] Sin embargo, otras variaciones citogenéticas de LLC se comportan de forma agresiva o muy agresiva y necesitan tratamiento después de pocos años desde su inicio. Si bien la LLC generalmente todavía no es una enfermedad curable, los avances en el tratamiento de la LLC han mejorado las perspectivas de forma significativa. Para pacientes con pronóstico menos favorable, la LLC progresa más rápidamente, pero los últimos tratamientos son más eficientes, mejor tolerados y controlan mejor la enfermedad por lo que se puede tener una buena calidad de vida durante muchos años.[5]
La Leucemia linfática crónica es la leucemia más frecuente, afecta sobre todo a adultos y su incidencia es mayor a edades avanzadas (mediana de 71 años), siendo más frecuente en hombres que en mujeres (2/1) y mucho más habitual en occidente que en oriente.[7] No debe ser confundida con la leucemia linfática aguda (LLA), un tipo de leucemia frecuente en niños. El médico especialista en leucemias es el hematólogo.
En el año 2010 se logró la secuenciación completa del genoma de la leucemia linfática crónica.[8][9] En 2015 se logró la secuenciación completa del genoma de 506 pacientes con LLC,[10] identificando 60 genes distintos y nuevas mutaciones recurrentes, que sugieren la posibilidad de mejorar las intervenciones clínicas en el manejo de esta neoplasia y diseñar tratamientos específicos para cada paciente.[11]
La incorporación de nuevos fármacos (anticuerpos monoclonales y terapias dirigidas por inhibidores de la tirosina kinasa) Bcl-2 y PI3K) ha reducido la toxicidad y mejorados las tasas de remisión de la enfermedad, aumenta la supervivencia y en determinados casos consigue una enfermedad mínima residual (EMR) que cronifica la enfermedad. Además de estas terapias el trasplante de médula ósea sigue siendo siendo una alternativa para determinados pacientes. Se están llevando a cabo estudios clínicos sobre terapias CAR-T o Terapia de linfocitos T con CAR en LLC.[12][13]
Diagnóstico
Directrices de referencia para el diagnóstico y el tratamiento de la LLC pueden encontrarse en el artículo de Michael Hallek de 2008 Guidelines for the diagnosis and treatment of cll y en la revisión de 2010 de Foon y Hallek Changing paradigms in the treatment of chronic lymphocytic leukemia.
Habitualmente la LLC se presenta en pacientes de edad avanzada. Un porcentaje alto de pacientes no presentan síntomas. La sospecha de LLC surge ante la aparición de leucocitosis (número elevado de linfocitos —más de 5000 por mm³— en un análisis de sangre rutinario).
Puede padecer anemia y anemia hemolítica, más raramente trombopenia (plaquetas bajas). El ácido úrico y la LDH suelen estar elevados. Se suele acompañar de hipogammaglobulinemia (concentración baja de inmunoglobina —anticuerpos— en sangre con alto riesgo de infección), especialmente de IgM. También se encuentran alteraciones de la inmunidad celular debido a la secreción de factores inhibidores por los linfocitos neoplásicos. Además pueden presentarse adenopatías (inflamación de ganglios linfáticos, bazo e hígado —hepatoesplectomegalia—). Una alimentación con deficiencia de hierro y ácido fólico favorece la aparición indicadores relacionados con una baja hemoglobina (p.e. anemia).
Indicadores y pruebas diagnósticas
- Hemograma: El recuento de linfocitos es superior a cinco mil por milímetro cúbico (5000/mm³),[14] pudiendo alcanzarse cifras muy superiores en el transcurso de la enfermedad. Hay que observar la relación entre el volumen linfocitos bajo (VCM) y conductividad alta (VCS).
- Microscopio: La observación microscópica de la sangre periférica permite comprobar la morfología de las células y confirmar la presencia de la enfermedad.
- Mielograma: El mielograma de médula ósea confirma la infiltración en los ganglios linfáticos de linfocitos pequeños de aspecto maduro al lado de los cuales pueden observarse otros de aspecto atípico que suelen formar seudofolículos. Esta prueba está en desuso ante la implantación de la biopsia de médula ósea.
- La biopsia de médula ósea permite conocer las variaciones citogenéticas y el inmunofenotipo.
- Citometría de flujo: Permite el diagnóstico diferencial con otras leucemia de tipo B y T. Es un estudio con marcadores de superficie.
- En la LLC hay una proliferación de linfocitos B. En ausencia de enfermedad hay un 80 % de linfocitos T y un 20 % de linfocitos B, en la LLC esta relación se invierte (del 80 al 95 % linfocitos B y del 5 al 20 % de linfocitos T), esta inversión es muy utilizada para el diagnóstico.
- El fenotipo típico de la LLC es CD19, CD5, CD23 positivo. El CD79b, el FMC-7 y las IgS son positivos débiles o negativos, y el CD22 es positivo débil.[15] Para otros autores la LLC más común presenta una proliferación de linfocitos B con expresión de CD19 , CD20 , CD22 y CD23 . En todo caso los antígenos CD son claves para el diagnóstico de esta enfermedad.[16]
- Citogenética: Aparecen alteraciones cromosómicas, las más frecuentes son: la deleción del brazo largo del cromosoma 13 (13q-) en el 50 % de los casos —variante típica—; la trisomía del cromosoma 12 ( 12) entre el 10 y el 30 % de los casos —variante atípica y proliferativa—; deleción en el cromosoma 11 entre el 10 y el 20 % de los casos; deleción del cromosoma 17 en un 10 % de los casos. También aparecen deleciones en el cromosoma 6 y translocaciones en el cromosoma 14.
- La exploración física, ecografía y TAC sirven para apreciar el estado general del paciente en relación con la detección las adenopatías propias de la enfermedad (aumento tamaño ganglios linfáticos y hepatoesplenomegalia —aumento de tamaño del hígado y el bazo—).
- Electroforesis de Proteínas séricas: Cuando la enfermedad avanza aparece hipogammaglobulinemia (carencia parcial o completa de anticuerpos). La disminución del vehículo de respuesta inmunitaria, las inmunoglobulinas(Ig) en su fracción gamma confirman el diagnóstico de LLC.[17]
- Test de Coombs:[18] Su positividad confirma la LLC y la presencia de anemia hemolítica autoimune.[19]
- Sombras de Gumprecht: La LLC clásica está formada por linfocitos pequeños con núcleo de cromatina madura y componiendo grumos (grumelé), escaso citoplasma y tendencia a romperse al realizar la extensión sanguínea, formando lo que se denomina Sombras de Gumprecht (la fragilidad de los linfocitos provoca su ruptura).
Diagnóstico diferencial
La Organización Mundial de la Salud considera la Leucemia linfática crónica (LLC) y el Linfoma linfocítico de células pequeñas (LLCP) variedades de la misma dolencia (un mismo tipo de linfoma no hodgkiniano), por lo que no deben ser considerados diferentes.[20]
En algunos casos la sangre periférica observada al microscopio parece similar a la LLC, pero presenta un fenotipo específico de células T por lo que se corresponde con la Leucemia prolinfocítica T.
Pronóstico
Además de la evolución particular de cada paciente y la aparición de modificaciones en el transcurso de la enfermedad se ha descrito la importancia de dos marcadores, la proteína-tirosina kinasa Zap-70 y el Cúmulo de diferenciación CD38, que condicionan altamente el pronóstico de esta enfermedad, de tal manera que hasta se discute si definen subtipos de esta enfermedad, el más plausible, ligado a la mutación o no en las regiones variables de los genes de las inmunoglobulinas (región VH); así, quienes tienen la mutación viven de media cuatro años más.[21]
- La deleción es la pérdida de material genético de un cromosoma (mutación) que puede ir desde la pérdida de un solo nucleótido (deleción puntual) hasta la pérdida de grandes regiones visibles citogenéticamente.
Complicaciones
Los enfermos de LLC pueden presentar entre otras, las siguientes complicaciones: anemia hemolítica autoinmune, aplasia medular (con anemia, granulocitopenia y trombocitopenia), esplenomegalia, hipogammaglobulinemia —disminución de inmunoglobulinas—, Infecciones de repetición (numerosas enfermedades infecciosas como herpes, neumonía...), así como diversas manifestaciones cutáneas.[22] Algunos pacientes sufren la transformación de su enfermedad en un tipo de leucemia de crecimiento rápido denominado Síndrome de Richter[23] o Linfoma difuso de células grandes B de mal pronóstico.[24]
Síntomas
Fase asintomática
El comienzo de la enfermedad suele ser asintomático (el paciente no se siente mal, nada le indica que esté enfermo). El hemograma muestra proliferación de linfocitos fuera de los rangos habituales.
El hematólogo hace un seguimiento periódico del estado general del enfermo mediante la comunicación con éste, la exploración física y la realización de pruebas necesarias, básicamente el hemograma (análisis de sangre).
La progresión de la enfermedad puede estabilizarse durante un tiempo o evolucionar apareciendo en los análisis de sangre de control aumento de linfocitos y leucocitos y nuevos indicadores (lactato deshidrogenasa, beta 2 microglobulina, plaquetas, hemoglobina, gamma globulina...) que superan o disminuyen el número o la proporción considerada normal pudiendo dar paso a la fase sintomática. Se incorporan nuevas pruebas como la ecografía, la tomografía Axial Computarizada, TAC o escáner y citometría para precisar la fase de la enfermedad y la situación concreta en el paciente.
Fase sintomática
La progresión inexorable de la LLC conlleva la aparición de los siguientes síntomas:[25]
- Inflamación de los ganglios linfáticos
- Inflamación del hígado (hepatomegalia) y/o el bazo (esplenomegalia)
- Sudoración excesiva, sudores fríos
- Fatiga
- Fiebre
- Infecciones recurrentes (vuelven a aparecer aún habiendo sido tratadas)
- Inapetencia o saciedad temprana (sentirse lleno con muy poca comida)
- Pérdida de peso involuntaria
- Hematomas anormales (en las últimas etapas de la enfermedad)
El hematólogo, a la vista del estado general del paciente, el hemograma, los resultados de otras posibles pruebas y los síntomas, establece el nivel de progresión y gravedad proponiendo, en su caso, el comienzo del tratamiento.
Estadios de evolución de la LLC: Rai y Binet
Los sistemas Rai (mediante números) y Binet (mediante letras) se utilizan para clasificar la enfermedad en relación con evolución y gravedad, desde unas etapas iniciales más leves a las últimas más graves. Se recomienda la integración de las dos escalas para el diagnóstico de la evolución: A(0), A(I), A(II); B(I), B(II); y C(III), C(IV).[26][27]
Sistema de Clasificación Rai
Clasificación Binet
Tratamiento
El tratamiento de la LLC consiste básicamente en el control de la enfermedad y sus síntomas mediante las terapias más idóneas para cada paciente. No puede hablarse de cura, excepto en los resultados favorables de trasplante de médula ósea. Puede consultarse el informe de posición de la SEHH de 2021 sobre acalabrutinib para conocer las distintas terapias para la LLC.[28] También, más antiguas, las directrices para el tratamiento pueden encontrarse en varios artículos (2008-2010).[29][30][31] Puede consultarse el artículo de 2015 de Morabito et al Promising therapies for the treatment of chronic lymphocytic leukemia[12] así como el resumen de la American Cancer Society sobre el tratamiento típico de la LLC. Puede consultarse revisión de tratamientos de 2018 en Nature Reviews Clinical Oncology.[32] Para tratamientos más actualizados puede consultar la página cancer.org sobre el tratamiento de la leucemia linfática crónica.[33] Puede consultarse el artículo de 2024 "Secuenciación del tratamiento de la leucemia linfocítica crónica en 2024: Dónde estamos y hacia dónde nos dirigimos" ("Treatment Sequencing in Chronic Lymphocytic Leukemia in 2024: Where We Are and Where We Are Headed").[34]
En los años 1940 la LLC se trataba con glucocorticoides, después con antineoplásicos alquilantes. Una técnica en desuso es la esplenectomía (extirpación del bazo)[35] que se realizaba cuando la esplenomegalia (bazo agrandado) contribuye a la trombocitopenia y a la anemia y siempre que haubieran fracasado la radioterapia y quimioterapia.[36]
La LLC se trata con terapia dirigida de inhibidores de tirosina kinasa e inhibidores Bcl-2, junto con terapia biológica (anticuerpos monoclonales), y, cuando se considera adecuada y no existe alternativa viable, el trasplante de médula ósea.
Desde la primera década del siglo XXI se han incorporado los anticuerpos monoclonales (Rituximab, obinutuzumab). En la segunda década del siglo XXI se incorporan los inhibidores de tirosina kinasa, y concretamente inhibidores de la tirosina Kinasa de Bruton (ibrutinib, acalabrutinib, zanubrutinib, pirtobrutinib (Jaypirca), tirabrutinib, vecabrutinib) e inhibidores Bcl-2 (venetoclax) e inhibidores selectivo de la Fosfoinositol 3-quinasa PI3K ((Idelalisib, duvelisib o umbralisib).[28][37]
Los tratamientos con inhibidores de BTK e inhibidores de BCL2 han sustituido al uso de la quimioinmunoterapia en la LLC, tanto en primera línea como en pacientes en recaída[34]
Terapias dirigidas e inmunoterapia
La aparición de medicamentos inhibidores de la tirosina quinasa específicios para la LLC como ibrutinib y acalabrutinib, entre otros, ha supuestos un cambio radical en las terapias para el control de la LLC. No obstante se siguen utilizando, por su eficacia, aplicación temporal y no permanente, en determinados pacientes, tratamientos tradicionales con quimioterapia. La inmunoterapia con anticuerpos monoclonales (rituximab, ofatumumab, obinutuzumab) se han unido a la terapia de la enfermedad en monoterapia o combinados con inhibidores.[28]
Terapias dirigidas con inhibidores de la tirosina quinasa, Bcl-2 y PI3K
En 2021 los medicamentos utilizados para las terapias dirigidas para la LLC son:[38]
- Ibrutinib (Imbruvica) - Desde febrero de 2014 el Ibrutinib está aprobado por la FDA para el tratamiento de la LLC previamente tratada.[39][40]
- Acalabrutinib (Calquence) - Aprobado por la EMA en 2020 para su uso en la Unión Europea para la LLC para la Unión Europea.[41][28]
- Idelalisib (Zydelig) -
- Duvelisib (Copiktra) - Inhibidor de PI3K, uso limitado en LLC recidivante/refractaria por sus efectos adversos.
- Venetoclax (Venclexta) - Fármaco inhibidor Bcl-2, muestra eficacia en deleción p17.[42]
- Pirtobrutinib (Jaypirca) - fármaco inhibidor Bcl-2, no covalente.[43]
Terapias dirigidas con inhibidores inmunoterapia
- Venetoclax Rituximab (terapia de duración determinada - 24 meses)
- Venetoclax Obinutuzumab[44]
- Idelalisib Rituximab - el Idelalisib, un inhibidor selectivo de la Fosfoinositol 3-quinasa (PI 3-quinasas o PI3K) junto al anticuerpo monoclonal Rituximab se utiliza en casos de presencia de deleción de 17p o mutación de TP53 no son adecuados para recibir ningún otro tratamiento.[28]
Terapias combinadas de inhibidores
- Inhibidores BTK (p.e. Ibrutinib Inhibidores BLC2 (Venetoclax) (terapia de duración determinada - 14 meses)[45]
Terapias en investigación
En 2025 se están investigando terapias con:
- Nemtabrutinib - Inhibidor de BTK de nueva generación.[46]
- Terapias CAR-T - en fase experimental, dirigidas a antígenos CD19 (lisocabtagene maraleucel).[47]
- Anticuperos biespecíficos - Epcoritamab (anti-CD20/CD3) y Mosunetuzumab.[48][49]
- Degradadores de proteínas (Protac) - NX-2127, gradación de BTK con actividad inmunomoduladora.[50]
- Inhibidores BCL-XL o MCL-1 - En desarrollo preclínico para resolver resistencia a venetoclax
- Moduladores del microambiente - Inhibidores de SYK o CXCR4
Quimioterapia (en desuso)
El uso de quimioterapia prácticamente ha desparecido por su toxicidad. La combinación de distintas opciones en quimioterapia pueden ser eficaces tanto en los primeros tratamientos como en las recaídas.[51] Las combinaciones de análogos de purina (como la fludarabina) con agentes alquilantes (como la ciclofosfamida) producen las tasas de respuesta más altas y una mayor supervivencia libre de progresión que tratamientos con un solo medicamento si bien estos medicamentos parecen haber encontrado sustitutos más idóneos. La adición a estas combinaciones de terapia biológica mediante anticuerpos monoclonales (rituximab, ofatumumab, Lumiliximab) mejoran los resultados. Los estudios clínicos se dirigen tanto a perfeccionar las combinaciones existentes como comprobar la validez de tratamientos de mantenimiento con terapia biológica cuando la baja toxicidad lo permite.
Combinaciones de quimioterapia (en desuso)
- FC-R - Fludarabina, Ciclofosfamida y Rituximab[52][53][52]
- O-FC - Ofatumumab - Fludarabina, Ciclofosfamida[54][31]
- BR o B R - Bendamustina Rituximab[55][56][57]
- Combinaciones anteriormente utilizadas en el tratamientos de la LLC
- FC - Fludarabina con Ciclofosfamida.[58] F-R - Fludarabina con Rituximab.[59] PC-R - Pentostatina, Ciclofosfamida, y Rituximab.[60] CVP - Ciclofosfamida, Vincristina y Prednisolona.[60] CHOP - Ciclofosfamida, Doxorrubicina, Vincristina y Prednisolona. FCM - Fludarabina, Ciclofosfamida y Mitoxantrona.[60] FCM-R o R-FCM - Rituximab - Fludarabina, Ciclofosfamida y Mitoxantrona.[61][62]
Terapia biológica o quimioinmunoterapia
La Terapia biológica o quimioinmunoterpia en el tratamiento del cáncer utiliza el propio sistema inmunitario para combatir el cáncer disminuyendo los efectos secundarios. Se consideran terapias biológicas el uso de interferones, las interleucinas, los factores estimulantes de colonias, los anticuerpos monoclonales, las vacunas, la terapia génica y los agentes inmunomoduladores no específicos.[63]
Anticuerpos monoclonales
En el tratamiento de la leucemia linfática crónica se utilizan los anticuerpos monoclonales (en inglés Mab -Monoclonal antibodys o Moab) que han mejorado los resultados de los tratamientos aportando menores efectos secundarios que la quimioterapia tradicional aunque no están exentos de ellos.[63] El tratamiento exclusivo con anticuerpos monoclonales resulta mucho menos efectivo que junto a la quimioterapia tradicional, sin embargo, los anticuerpos monoclonales muestran eficacia en las terapias de mantenimiento —una vez realizado el tratamiento de choque inicial—, ya que prolongan el tiempo de remisión retrasando y controlando la reactivación de la enfermedad.
El anticuerpo monoclonal más usado en el tratamiento de la LLC es el rituximab[64] o rituxan (anticuerpo quimérico murino/humano —obtenido de rata y humanizado—[65] CD20, marca Mabthera, empresa suiza Roche), también se utiliza el alentuzumab —anticuerpo-CD52—, habitualmente en pacientes refractarios a la fludarabina.[66] (marca Campath). Nuevos anticuerpos como el ofatumumab,[67] anticuerpo humanizado HuMax CD20 (marca Arzerra, empresa británica GlaxoSmithKline y empresa danesa Genmab A/S), lumiliximab (anticuerpo CD23, empresa suiza Biogen) podrán mejorar el arsenal terapéutico para el tratamientos de la LLC.[68][69]
Trasplante de médula ósea
El trasplante de médula ósea consigue erradicar y curar la enfermedad en una parte de los enfermos, pero la tasa de mortalidad es elevada (22-40 %) y supervivencia baja (41-50 %), por lo que solamente debe considerarse en casos excepcionales.[70]
El tratamiento mediante trasplante de médula ósea es más efectivo cuando la leucemia está en remisión, normalmente una vez aplicada la quimioterapia y antes de una posible reactivación.[71]
El trasplante de médula ósea puede ser del mismo paciente (trasplante autólogo) o de otra persona (trasplante alogénico). El trasplante alogénico tiene distintas variedades según el donante: si es un hermano gemelo univitelino se denomina trasplante singénico, cuando es un familiar HLA idéntico se denomina trasplante alogénico de hermano HLA idéntico; si es un familiar que comparte un solo haplotipo del sistema HLA se denomina trasplante haploidéntico, si no hay parentesco se denomina trasplante de donante no emparentado. A mayor identidad mayores posibilidades de éxito.[72]
Antes del trasplante se deben eliminar las células presentes en la médula ósea del paciente (mediante quimioterapia y/o radioterapia) para permitir el implante de la médula ósea del donante. En el caso de un trasplante alogénico haploidéntico o de donantes no relacionados es necesario utilizar medicamentos inmunosupresores para evitar el rechazo.
Las alternativas al trasplante de médula ósea consisten en el trasplante de progenitores hematopoyéticos aislados de la sangre periférica o de cordón umbilical. El objetivo es inocular en los pacientes únicamente los progenitores hematopoyéticos (conocidas también como células madre hematopoyéticas) que tienen la capacidad de implantarse en la médula ósea de un paciente y dar lugar a un sistema inmune sano.
Existen numerosos protocolos y estudios clínicos en desarrollo.[73]
Terapia genética en leucemia
La terapia genética podría convertirse en una alternativa real a los trasplantes de médula ósea y a la quimioterapia si los ensayos confirmaran su seguridad y eficacia. En 2011 tres pacientes con leucemia linfática crónica respondieron favorablemente a dicha terapia.[74][75] En 2013 6 estudios confirmarían que tratamientos genéticos -Terapia de linfocitos T con CAR- (CTL019 o CART19) habrían trasformado las células de la sangre del paciente en “soldados” que atacan el cáncer.[76][77][78][79]
Genoma de la leucemia linfática crónica
Proyecto genoma de la LLC (2009-2012)
Dentro del proyecto mundial para la secuenciación del genoma del cáncer gestionado por el Consorcio Internacional del Genoma del Cáncer ICGC España es la encargada de la secuencia genómica de la leucemia linfática crónica Archivado el 16 de marzo de 2020 en Wayback Machine.. El objetivo es secuenciar el genoma en numerosos pacientes y poder establecer las homogeneidades, las variabilidades y, en su caso, un diagnóstico más personalizado y eficaz.[80] El 15 de abril de 2010 fueron publicados en Nature los avances de los primeros resultados de los primeros 5 genomas completos de pacientes con LLC.[81][82]
Organismos participantes
El organismo director y financiero es el Instituto de Salud Carlos III [2] (organismo público dependiendo del Ministerio de Ciencia e Innovación de España).[83] La dirección científica del proyecto corre a cargo del Dr. Elías Campo[3] y del Dr. Carlos López Otín.[84] Dos de las instituciones que participan y que tienen más tradición y reconocimiento en LLC son el Hospital Clínico y Provincial de Barcelona [4] (Instituto Clínic de Enfermedades Hematológicas y Oncológicas (ICMHO) y el Centro de Investigación del Cáncer de Salamanca (CIC) - (Servicio de Hematología del Hospital Universitario de Salamanca). También participan la Universidad de Oviedo, el Centro de Regulación Genómica de Barcelona, el Instituto Catalán de Oncología, la Universidad de Deusto, el Centro Nacional de Investigaciones Oncológicas, el Banco Nacional de ADN y la Universidad de Barcelona, con el apoyo técnico para la investigación de la Red Temática en Investigación Cooperativa en Cáncer (RTICC).[85]
Publicación en Nature del genoma de la LLC en junio de 2011
El 5 de junio de 2011 fue publicado en la revista Nature el artículo —remitido en diciembre de 2010— Whole-genome sequencing identifies recurrent mutations in chronic lymphocytic leukaemia (Secuenciación completa del genoma de la leucemia linfática crónica con identificación de las mutaciones recurrentes) fruto del trabajo del equipo español responsable del genoma de la LLC[86] y miembro del International Cancer Genome Consortium.[8][9]
Red europea de leucemia - European Leukemianet - ELN
LeukemiaNet es una red europea para el avance de la investigación contra la leucemia que reúne grupos de estudio nacionales que representan a 147 instituciones de 28 países. En total participan en el estudio más de mil investigadores y cerca de diez mil pacientes.[87][88]
Estudios preclínicos
En 2012, estudios preclínicos farmacológicos, confirmarían posibles efectos antitumorales —especialmente en leucemias—, del diterpeno hispanolona, una molécula que se encuentra en la Galeopsis angustifolia y en la Ballota hispanica o manrubio rojo.[89][90][91]
Causas - Etiología
Aunque se desconocen las causas específicas (etiología) que provocan la LLC todos los pacientes presentan modificaciones anormales en los cromosomas de las células. El protooncogen Bcl-2 (B-cell lymphoma 2) aparece sobreexpresado. En la mayoría de los casos aparecen alteraciones secundarias en la expresión de los Micro ARN (miRNA en inglés) MIRN15a y MIRN16-1.[92] Dependiendo de la naturaleza de dichas alteraciones se han establecido pronósticos distintos en relación con la evolución y gravedad de la enfermedad.
No se considera una enfermedad hereditaria aun cuando existen antecedentes familiares en algunos casos. No hay una causalidad comprobada con la historia clínica del paciente (otras enfermedades o circunstancias del enfermo) y no está establecida relación directa con radiaciones, tóxicos u otras sustancias externas. [cita requerida]
Son posibles causantes de la enfermedad aquellas factores externos o internos que producen las alteraciones celulares descritas en la LLC.
Origen en un citomegalovirus de la familia de los herpes
Un estudio de 2012 publicado en la revista Blood estableció que un antígeno que se une a los receptores celulares de leucemia es la proteína pUL32 de un citomegalovirus humano de la familia de los herpes. Si el citomegalovirus fuera el origen de la leucemia podría estudiarse el tratamiento de antivirales para frenar el avance de la enfermedad.[93][94]
Infecciones por hongos
Varios artículos señalan las infecciones por hongos, en concreto Coccidioides como posibles causantes de la LLC [95]
Tóxicos cancerígenos y hemotóxicos
Distintos componentes químicos orgánicos e inorgánicos han sido catalogados como cancerígenos y específicamente hemotóxicos, entre ellos están los compuestos organofosforados,[96] organoclorados, utilizados como pesticidas, plaguicidas e insecticidas; el acetato de vinilo,[97] y también el benceno,[98] El benceno es un compuesto químico muy utilizado en la industria y presente la gasolina, en pinturas, y en el tóner de fotocopiadoras e impresoras. El benceno también está presente en el humo del tabaco. La exposición prolongada a niveles altos de benceno en el aire puede producir leucemia, especialmente leucemia mieloide aguda[99] En 2014 la compañía Samsung reconoció el vínculo entre las condiciones de trabajo de sus fábricas —de semiconductores— y la aparición de leucemia. otros cánceres de sangre y otras enfermedades.[100]
Radiación ionizante - radiactividad
Tradicionalmente se considerada que la leucemia linfática crónica no estaba causada por la radiación ionizante, pero se está poniendo en duda, tanto por las dudas sobre los estudios existentes: dificultad de relacionar la radiación con la enfermedad —que tiene un largo período de latencia— como por la causa de muerte de numerosos pacientes que aparece como distinta a la LLC aun cuando estos la padecían. Es decir, muchos de los estudios históricos se consideran demasiado simples e insuficientes.
En 2006 han aparecido nuevos datos sobre trabajadores mineros expuestos al radón en la República Checa que presentan una alta incidencia de LLC. Del mismo modo, en aquellos que trabajaron en la limpieza del Accidente de Chernóbil (los liquidadores) y han sufrido LLC se ha encontrado una virulencia especial en la enfermedad así como mayor riesgo de padecer síndrome de Richter.[101]
Otras causas posibles
Aun cuando no existen causalidad reconocida diversos estudios establecen ciertas correlaciones y sugieren indicios, a veces muy tenues, que deben verificarse y ser aceptadas por la comunidad científica.
Exposición crónica a campos electromagnéticos
La radiación electromagnética y sus posibles efectos sigue siendo motivo de preocupación y estudio por las autoridades sanitarias con resultados ambivalentes. Así, por ejemplo, en el punto 10.3 de las conclusiones del Comité Científico de los riesgos sanitarios emergentes y recientemente identificados sobre campos electromagnéticos de la Comunidad Europea se indica:[102]
El Doctor Alejandro Úbeda Maeso, del Hospital Ramón y Cajal de Madrid, miembro del Proyecto Reflex,[104][105][106] indica que:
Véase también
- Portal:medicina. Contenido relacionado con medicina.
- Hematología
- Linfoma - Leucemia
- Linfoma no hodgkiniano
- Leucemia prolinfocítica
- Leucemia mieloide crónica
- Leucemia linfoide aguda
- Anexo:CIE-10 Capítulo II: Neoplasias
Referencias
Enlaces externos
- ICGC - International Cancer Genome Consortium Consorcio Internacional del Genoma del Cáncer
- ICGC - Spain - Chronic Lymphocytic Leukemia Archivado el 16 de marzo de 2020 en Wayback Machine.
- Diccionario del Cáncer en línea - Instituto Nacional del Cáncer
- ELN - European Leukemianet - Página principal-
- The European Group fro Blood and Marrow Transplantation
- En español
- Leucemia linfática crónica, en Leukemia & Lymphoma Society (enlace roto disponible en Internet Archive; véase el historial, la primera versión y la última).
- Una nueva combinación terapéutica aumenta la supervivencia en Leucemia Linfática Crónica, Blog Hospital Clínico de Barcelona 8 de septiembre de 2009
- Las alergias se asocian a menos riesgos de desarrollar linfomas no Hogkin, Diario Médcio, 24 de septiembre de 2009 (enlace roto disponible en Internet Archive; véase el historial, la primera versión y la última).
- España estudiará la leucemia linfática crónica, un trabajo dirigido por el Clínico de Barcelona con gran protagonismo del Centro Internacional del Cáncer salmantino 4 de diciembre de 2008
- aeal ¿qué es la LLC?
- Significación biológica y marcadores pronósticos de la leucemia linfática crónica y entidades relacionadas, Emili Montserrat, S. Hematología. Hospital Clínic i Provincial. Barcelona. Adap, Josep Gumà Padró. S. de Oncología del Hospital St. Joan de Reus Archivado el 4 de agosto de 2009 en Wayback Machine.
- Leucemia linfoide crónica, Hospital de Clínicas Dr. Manuel Quintela, Universidad de la República, Uruguay junio de 2006
- Identificada la primera mutación genética heredada asociada al desarrollo de leucemia -alteración DKP1-, Jano Online, 1/6/2007, en español en 'Instituto de Hematología e Inmunología. Cuba
- En inglés
- Guidelines for the diagnosis and treatment of CLL - Hallek et. al. - Artículo de referencia de Michael Hallek y col -2008-
- Tópicos de LLC - ONG educacional
- Consorcio de Estudios de LLC Archivado el 21 de octubre de 2009 en Wayback Machine.
- Sociedad de Leucemia & Linfoma
- Lymphomation.org - Sitio de Linfoma con recursos de LLC
- Instituto Nacional de Cáncer de EE. UU.
- Sitio de ACOR - ONG ACOR (Asociación del Cáncer Online). Se recibe correos electrónicos de otros miembros de la lista
- CLLResearch - Grupo dedicado a estudios de LLC
- Blog: David Arenson's CLL Diary
- CLL Forum - Foro para miembros, comunidad moderada, global con soporte amigable, información y recursos para sujetos con LLC y sus cuidadores.
- CLL Canada - Repositorio de estudios de LLC en términos legales.
- UK Asociación de Soporte de LLC